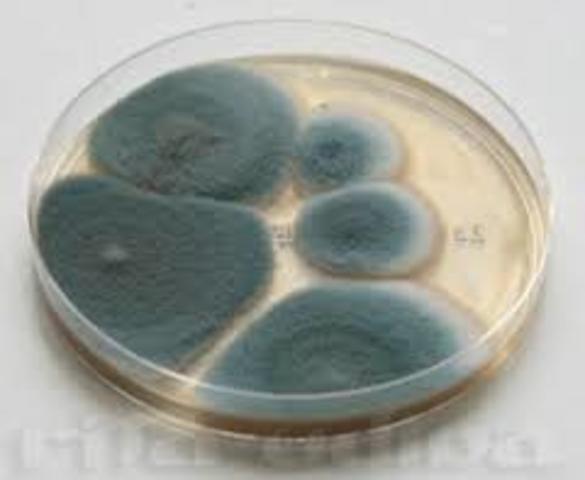
CULTIVACION DE VIRUS EXITOSAS

-
Es el pirmero en hablar de ” semillas de enfermedad”. conocidos como Organimos invisibles para el ojo humano e indetectables para el ser humano convirtiendolas en un enemigo.
-
Este periodo se inicia desde los 3 a 2.5 millones de años A.C con la evolucióndel genero homo. Al desarrollarse las primeras prácticas agrícolas y elprocesamiento empírico de los alimentos (10000-7000 A.C) el hombre inicia inconscientemente su relación eterna con los microorganismos. Fueron los sumerios, babilonios y, más exquisitamente, los egipcios los que emplearon directamente a los microorganismos al desarrollar la fabricación del pan y lacerveza
-
Girolamo estudia las enfermedades contagiosas y propone una teoría sobre su origen para poder analizar el estudio de los efectos y causas que generan en el en el cuerpo humano.
-
invencion de la sifiis.
-
Robert Hooke creó el primer microscopio compuesto, en el cual se utilizaban dos sistemas de lentes, las lentes oculares (u ocular) para visualizar y las lentes objetivos.
-
FRANCISCO REDI A TRAVES DE MULTIPLES EXPERIMENTOS CON CARNE EN ESTADO DE PUTREFACCION O DESCOMPOSICION POSTULA LO INCORRECTO DE ESTA TEORIA AL VER QUE LOS MICROORGANISMOS PRESENTE EN EL TEJIDO MUSCULAR CRECEN A BASE DE LA DEGRADACION DE ESTA CARNE
-
El holandés Antoni Van Leeuvenhoek fabricó sus propios microscopios simples, que lo llevaron al descubrimiento de los glóbulos rojos en , así como también al descubrimiento de las bacterias y del esperma humano.
-
describieron observaciones microscópicas de hongos
-
Fue el primero en realizar importantes observaciones con microscopios fabricados por él mismo y como uno de los precursores de la biología experimental y de lo que posteriormente se conocería como biología celular y microbiología.
-
Después que las publicaciones de
Leewenhoek demostraron la existencia delos microorganismos fue necesario, esperar cerca de 200 años para que la microbiología tenga un avance rápido. Esto fue debido principalmente al predominio en aquella época de la Teoría de la Generación espontánea. Este fue un periodo de duro enfrentamiento filosófico entre los diversos científicos que termino con tal Teoría. Hombres como
Francesco Redi (1626 1698), Lázaro Spallanzani (1729 1799), Jhon Tyndall -
Antony van Leeuwenhoek describe las primeras observaciones realizadas con microscopios caseros de los microorganismos (llamados entonces animáculos) presentes en agua de lluvia, fuentes, mar y nieve así como de muestras tomadas de materia interdental.
-
En el año de1796, Jenner registró los casos de viruela humana y animal e intuyó que la viruela del ganado podía dar inmunidad frente a la viruela humana clásica. Esta hipótesis tuvo su prueba cumbre en 1796, cuando en una epidemia de viruela Jenner logró extraer pequeñas gotas de pus de las pústulas presentes en una mujer campesina que había entrado en contacto con la viruela animal. Estas gotas fueron sembradas en el brazo de un niño y con ello se obtuvo, además de la cicatriz, la inmunidad
-
desarrolla el método de esterilización de alimentos envasados conocido como appertización o preservacion de alimentos
-
François Appert desarrolla el método de esterilización de alimentos envasados conocido como appertización.
El maestro confitero Nicolás Appert consiguió este premio en 1810 después de 14 años de experimentación. Su procedimiento consistía en colocar los alimentos en botellas de vidrio tapadas con tapones de corcho sujetos con alambre y sellados con cera o lacre que sometía a un calentamiento en agua hirviendo durante largo tiempo. -
Lázaro Spallanzani comprobó que el tratamiento térmico repetido permitía evitar el crecimiento de microorganismos en infusiones. Supone un primer desarrollo de métodos de esterilización de líquidos.
-
Theodore Schwann realiza los primeros experimentos relacionados con la fermentación y la putrefacción originados por microorganismos.
-
En el año 1864, a instancias del emperador Napoleón III, Pasteur investigó la causa por la que el vino y la cerveza se agriaban con el paso del tiempo, causando grandes pérdidas económicas a las empresas francesas debido a lo perecedero de estas mercancías. Pasteur regresó al pueblo de su infancia, Arbois, con el objetivo de resolver el problema definitivamente. Allí estudió el problema que afectaba a las viñas. Con ayuda de un microscopio, descubrió que intervenian dos tipos de organismos.
-
Joseph Lister desarrolla el principio de la asepsia en la práctica quirúrgica. mediante el empleo de unos quimicos quirurgicos evito el principal problema de la medicina la contacion de heridas y putrefacion ocacionada por la gangrena, mediante el empleo de estas sustancias, calor y esterilizacion logro eliminar o controlas las bacterias responsables que se encontraban en el ambiente como en los medicos
-
realiza una serie de experimentos que demuestran el origen microbio de procesos de fermentación láctica, alcohólica, existencia de microorganismos anaerobios y demuestra que sólo puede producirse crecimiento.
-
El aleman Flemming investigó también el proceso de la división celular y la distribución de los cromosomas en el núcleo hermano, proceso que denominó mitosis, de la palabra griega para el hilo. Sin embargo, no se dio cuenta de la separación en dos mitades idénticas, las cromátidas hermanas
-
John Tyndall. Desarrolla un método que permite la esterilización de líquidos que contienen esporas de bacilos.
-
William James Beal. Éste botánico estadounidense desarrolló cruces de maíz valiéndose de sus conocimientos científicos, consiguiendo al finalizar su experimento en 1879 mejorar la producción de maíz en un 50%. Dando origen a la modificacion exitosa de genes en alimentos aumentando su calidad de produccion, resistencia y calidad
-
En 1884, el microbiólogo francés Charles Chamberland inventó un filtro (conocido actualmente como filtro Chamberland o filtro Chamberland-Pasteur) que tiene poros de tamaño inferior al de una bacteria. Así pues, podía hacer pasar por el filtro una solución con bacterias y eliminarlas completamente de ella.
-
La tinción de Gram o coloración de Gram es un tipo de tinción diferencial empleado en bacteriología para la visualización de bacterias, sobre todo en muestras clínicas. Debe su nombre al bacteriólogo danés Christian Gram que desarrolló la técnica en 1884. Se utiliza tanto para poder referirse a la morfología celular bacteriana, como para poder realizar una primera aproximación a la diferenciación bacteriana.
-
la vacuna contra la rabia con éxito por Louis Pasteur en 1886. Sin embargo la naturaleza del virus no era clara para los investigadores. mediante el ailamiento de este virus logro aislar un anticuerpo que sirviera para curar y controlar el virus que se estendia por el mundo
-
realiza los primeros estudios sobre los efectos geoquímicos producidos por bacterias.
-
Aisla bacterias fijadoras de nitrogeno de los nodulos presentes en las raices de leguminosas.
-
M.V.Beijerinck aisló el primer virus vegetal (Mosaico del tabaco).
el virus del mosaico del tabaco es un virus de ARN monocatenario positivo. Es decir, cuando entra en una célula vegetal su ARN será transcrito por la ARN polimerasa dependiente de ARNa múltiples ARN de hebra negativa, que darán lugar a proteínas infectivas. Su estructura está formada por una envuelta cilíndrica de unos 18 nm de diámetro y unos 300 nm de longitud y hueca, en su interior hay un canal de 4 nm. Esta cubierta está for -
El proceso de producción de acetona y butanol por bacterias fue descubierto en1914 por
Chaim Welzmann
Cuando estallo la primera guerra mundial en agosto de ese año, la producción de acetona era esencial en el proceso de fabricación de las municiones, por lo que el descubrimiento de
Weizmann
jugo un papeldeterminante en el desarrollo de la guerra. -
OS BACTERIOFAGOS Al igual que los virus que infectan células eucariotas, los fagos están constituidos por una cubierta proteica o cápside en cuyo interior está contenido su material genético, que puede ser ADN , de 5.000 a 500.000 pares de bases. El tamaño de los fagos oscila entre 20 y 200 nm aproximadamente.
-
se puso en operación exitosa la primera planta mundial de ácidocítrico por Pfizer, que utilizaba la fermentación de la sacarosa por
Asperigillus Níger -
Alexander Fleming descubre la penicilina Las penicilinas son antibióticos del grupo de los betalactámicos empleados profusamente en el tratamiento de infecciones provocadas por bacterias sensibles. La mayoría de las penicilinas son derivados del ácido 6-aminopenicilánico, difiriendo entre sí según la sustitución en la cadena lateral de su grupo amino. La penicilina G o bencipenicilina fue el primer antibiótico empleado ampliamente en medicina
-
El descubrimiento causal de
1928 de la antibiosis de Penicilium notatum
contra Streptococcus aureus debido la penicilina -
En 1931 fue mostrado que ese virus de la gripe podría cultivarse en huevos de pollo fertilizados, un método que todavía se utiliza hoy para producir vacunas. dado que no compremete la vida humada y es una condicion de engrendacion controlable
-
nvención de la microscopía electrónica en 1931 por parte de los ingenieros alemanes Ernst Ruska y Max Knoll, se obtuvieron las primeras imágenes de virus Un microscopio electrónico
E este aquél que utiliza electrones en lugar de fotones o luz visible para formar imágenes de objetos diminutos. Los microscopios electrónicos permiten alcanzar ampliaciones antes que los mejores microscopios ópticos, debido a que la longitud de onda de los electrones es mucho menor que la de los fotones "visibles". -
En 1944 Oswald Avery al frente de un equipo del Rockefeller Institute de Nueva York aportan las primeras pruebas solidas de que en el ADN están codificados los genes que determinan las cualidades de cada ser vivo.
-
frascatoro, sugirió que las enfermedades son causadas por organismos invisibles o "fomites" y se transmiten de una persona a otra.
-
El experimento de Hershey-Chase en 1952 mostró que sólo el ADN y proteínas no entra en una célula bacteriana a infección con bacteriófago T2. Transducción de bacterias por bacteriófagos fue descrita por primera vez en el mismo año.
-
en 1965 Howard Temin describió el primer retrovirus
un virus ARN que fue capaz de insertar su genoma en forma de ADN en el genoma del huésped. -
En 1963 Baruch Blumberg descubrió el virus de la hepatitis B
es una enfermedad del hígado causada por el virus de la hepatitis B, perteneciente a la familia Hepadnaviridae (virus ADN hepatotrópico). Es una enfermedad infecciosa del hígado causada por el virus y caracterizada por necrosis hepatocelular e inflamación. Puede causar un proceso agudo o un proceso crónico, que puede acabar en cirrosis (pérdida de la "arquitectura" hepática por cicatrización y surgimiento de nódulos de regeneración) -
Holley aisló los tRNA, moléculas que incorporan los aminoácidos activados en las proteínas.es un tipo de ácido ribonucleico encargado de transportar los aminoácidos a los ribosomas y ordenarlos a lo largo de la molécula de ARNm, a la cual se unen por medio de enlaces peptídicos para formar proteínas durante el proceso de síntesis proteica. Existe una molécula de ARNt para cada aminoácido, con una tripleta específica de bases no apareadas, el anticodón.
-
Allan Maxam y Walter Gilbert desarrollaron un método para secuenciar ADN basado en la modificación química del ADN y posterior escisión en bases específicas8 Aunque Maxam y Gilber publicaron su secuenciación química dos años antes.
-
Sus análisis filogenéticos en 1977 lo llevaron al descubrimiento de un nuevo dominio, Archaea.
-
En 1983, el equipo de Luc Montagnier del Instituto Pasteur de Francia aisló por primera vez el retrovirus, actualmente llamado VIH PRINCIPAL CAUSA DEL SIDA
-
La primera droga antirretroviral, con capacidad de bloquear la enzima transcriptasa reversa, también fue descubierta en 1987. Esta droga, el AZT (azidotimidina), fue el primer paso en el desarrollo de una terapéutica específica antiviral. En 1995 aparecieron los inhibidores de proteasa como un nuevo grupo de fármacos y se desarrolló el esquema de terapia antirretroviral altamente activa (HAART, por sus siglas en inglés).
-
a clonación animal a partir de una célula adulta es mucho más difícil que de una célula embrionaria. Así pues, cuando los investigadores del Instituto Roslin de Escocia crearon a Dolly, único cordero nacido después de 277 intentos Para fabricar a Dolly, los investigadores usaron una célula de ubre de una oveja blanca de la raza Finn Dorset de seis años de edad. Tuvieron que encontrar un modo de 'reprogramar' las células de ubre para mantenerlas vivas sin que crecieran.
-
Descubren una bacteria (Candidatus Desulforudis audaxviator) a 2500 m de profundidad
Looking for a timeline maker?
Create timelines for projects, roadmaps, history, lessons, legal cases, and stories with Timetoast. Timetoast is a timeline maker for work, school, research, and stories.